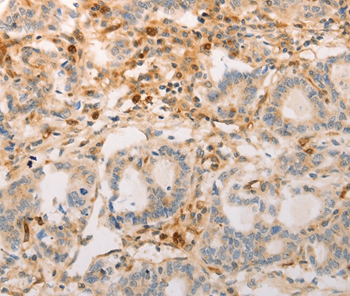
Rabbit Polyclonal Antibody to AVPR2

提醒成功

搜索
Rabbit Polyclonal Antibody to AVPR2
-
货号:
P42842 -
别名:
DI1; DIR; NDI; V2R; ADHR; DIR3 -
应用:
IHC -
反应种属:
Human -
抗体类型:
Primary antibody -
Swissprot:
P30518 -
规格:
-
数量:
-+ -
说明书:
目录价¥1980

Rabbit Polyclonal Antibody to AVPR2
Description |
|---|
This gene encodes a member of the ASPP (apoptosis-stimulating protein of p53) family of p53 interacting proteins. The protein contains four ankyrin repeats and an SH3 domain involved in protein-protein interactions. It is localized to the perinuclear region of the cytoplasm, and regulates apoptosis and cell growth through interactions with other regulatory molecules including members of the p53 family. Multiple transcript variants encoding different isoforms have been found for this gene. |
Specification |
|
|---|---|
| Aliases | DI1; DIR; NDI; V2R; ADHR; DIR3 |
| Entrez GeneID | 554; |
| Swissprot | P30518 |
| Host/Isotype | Rabbit IgG |
| Antibody Type | Primary antibody |
| Storage | Store at 4°C short term. Aliquot and store at -20°C long term. Avoid freeze/thaw cycles. |
| Species Reactivity | Human |
| Immunogen | Synthetic peptide corresponding to residues near the C terminal of human arginine vasopressin receptor 2 |
| Formulation | Liquid in PBS containing 50% glycerol, 0.5% BSA and 0.02% sodium azide. |
Application |
|
|---|---|
| IHC | 1/25-1/100 |
Product Image
For Reseach Only
Application Key:WB - Western Blot | IHC - Immunohistochemistry | ICC - Immunocytochemistry | FCM - Flow Cytometry | ELISA - Enzyme-linked Immunosorbent Assay | IP - Immunoprecipitation
#P42842

相关产品















 微信/QQ登录
微信/QQ登录


 首页
首页